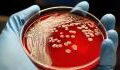
Forscher finden heraus: Dieses Bakterium hat es auf menschliches Blut abgesehen

Manche Menschen gehen ständig Blut spenden (wie Star-Kicker Cristiano Ronaldo), anderen hingegen wird schon beim kleinsten Tropfen Blut schlecht. Kopfschmerzen, verschwommenes Sehen, plötzliches Schwitzen, ein blasses Gesicht, weiche Knie:
Der Anblick von ein paar Tropfen Blut verursacht bei einigen Menschen - ja, auch bei Männern - ein echtes Unbehagen, das manchmal sogar zu Ohnmacht führen kann. Das Phänomen nennt sich Blutphobie.
Gefahr Blutverlust
Der Blutverlust ist eine echte Gefahr für den Körper. Je mehr Blut wir sehen, desto größer ist die Bedrohung, die der Körper erfährt. Sie erfordert eine schnelle Anpassung: Der Körper wird daher versuchen, die Verluste so weit wie möglich zu begrenzen.
Dazu nutzt er das autonome Nervensystem, genauer gesagt das parasympathische Nervensystem. Es kümmert sich um alle unfreiwilligen und reflexartigen Aktivitäten des Körpers wie Atmung, Herzschlag, usw.

Unterversorgung von Sauerstoff im Gehirn
Bei Blutverlust versetzt dieses System den Körper in einen Zustand, der es ihm ermöglicht, Blut zu speichern: Die Herzfrequenz verlangsamt sich, die Atmung wird langsamer und der Blutdruck sinkt. Dadurch wird die Sauerstoffversorgung des Gehirns reduziert, was dann bei einer großen oder verlängerten Reaktion zu Symptomen wie Ohnmacht führt.
Leider kann diese übermäßige Reaktion des Körpers bei manchen Menschen schon beim Anblick eines einzigen Tropfens Blut auftreten. Bei anderen tritt es auch dann auf, wenn fremde Personen bluten. Laut Spezialisten ist dies einfach auf unsere Empathie zurückzuführen.
Ohnmacht vorbeugen
Es gibt jedoch Möglichkeiten, das Unwohlsein zu lindern und eine Ohnmacht zu vermeiden. In der Regel treten die Symptome nach und nach auf, bevor sie sich verstärken. Es ist daher möglich, das Unbehagen vorherzusagen und entsprechend zu handeln. Zum Beispiel kann es manchmal hilfreich sein, etwas frische Luft zu schnappen oder den Raum zu lüften, um die Symptome zu reduzieren.
Die Anspannung der Muskeln, insbesondere der Beine, kann auch eine gute Idee sein, um eine normale Durchblutung wiederherzustellen. Wenn die Beschwerden bereits fortgeschritten sind, ist es besser, sich mit angehobenen Beinen hinzusetzen oder hinzulegen, um das Gehirn gut mit Sauerstoff zu versorgen.